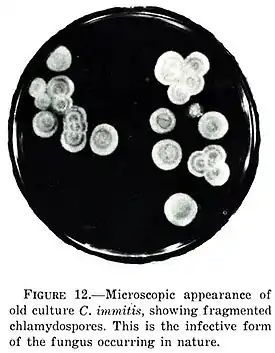

Coccidioides immitis
Coccidioides immitis — патогенный вид грибов семейства онигеновых, обитающий в почве. Встречается в некоторых регионах юго-западных США, северной Мексики, а также в нескольких других областях Западного полушария[1].
| Coccidioides immitis | ||||||||||
|---|---|---|---|---|---|---|---|---|---|---|
| ||||||||||
| Научная классификация | ||||||||||
|
Домен: Царство: Подцарство: Отдел: Подотдел: Класс: Подкласс: Eurotiomycetidae Порядок: Семейство: Род: Coccidioides Род: Coccidioides immitis |
||||||||||
| Международное научное название | ||||||||||
| Coccidioides immitis G.W.Stiles (1896) | ||||||||||
| Синонимы | ||||||||||
|
||||||||||
| ||||||||||
Эпидемиология
C. immitis, наряду с родственным видом C. posadasii,[2] встречается главным образом в пустынных регионах юго-зпадных США, включая определённые регионы Аризоны, Калифорнии, Нью-Мексико, Невады, Техаса и Юты, в Центральной и Южной Америки, включая Аргентину, Бразилию, Колумбию, Гватемалу, Гондурас, Мексику, Никарагуа, Парагвай и Венесуэлу[3].
Клинические проявления
C. immitis может вызвать заболевание, называемое кокцидиоидомикоз (болезнь Посады-Вернике; калифорнийская лихорадка)[4][5][6]. Инкубационный период варьируется от 7 до 21 дня[7]. Кокцидиоидомикоз сложно диагностировать на основании жизненно важных признаков и симптомов, которые обычно являются нечёткими и неспецифичными. Даже рентгенография грудной клетки или компьютерная томография не могут надежно отличить её от других заболеваний лёгких, включая рак лёгких. Для диагностики необходимы анализы крови или мочи для выявления антигенов кокцидиоидов. Однако, поскольку грибок создает массу, которая может имитировать опухоль легкого, для правильного диагноза может потребоваться образец ткани (биопсия). Кроме этого, используется метенаминовая окраска серебром Грокотта-Гомори для подтверждения присутствие в ткани характерных шариков организма Coccidioides.
Примечания
- Infectious Disease Index: Coccidioides immitis. MDSC Online. Public Health Agency of Canada (PHAC). Дата обращения: 16 июля 2013.
- Coccidioides group database. Broad Institute. Дата обращения: 11 июля 2013.
- Frederick S. Fisher, Mark W. Bultman, Demosthenes Pappagianis. Operational Guidelines (version 1.0) for Geological Fieldwork in Areas Endemic for Coccidioidomycosis (Valley Fever). U.S. Geological Survey Open-File Report 00-348 Version 1.0. U.S. Department of the Interior. Дата обращения: 12 июля 2013.
- Symptoms of Valley Fever | Coccidioidomycosis | Types of Fungal Diseases | Fungal | CDC
- Coccidioidomycosis (Valley Fever). Centers for Disease Control and Prevention (CDC). Дата обращения: 11 июля 2013.
- Fungal pneumonia: a silent epidemic - Coccidioidomycosis (valley fever). Centers for Disease Control and Prevention (CDC). Дата обращения: 11 июля 2013.
- Loretta S. Chang, Tom M. Chiller. Infectious Diseases Related To Travel. Centers for Disease Control and Prevention (CDC). Дата обращения: 12 июля 2013.
Ссылки
- Кокцидиоидомикоз. Справочник MSD. Дата обращения: 6 июля 2019.